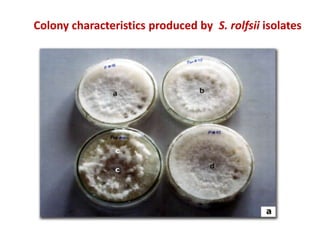
Colony characteristics produced by S. rolfsii isolates

The document discusses the biochemical and molecular characterization of Sclerotium rolfsii as a potential mycoherbicide against the invasive weed Parthenium hysterophorus. It outlines the harmful impacts of Parthenium on biodiversity and agriculture, and presents research findings on the growth characteristics, pathogenicity, and enzymatic activities of various S. rolfsii isolates. The study indicates that these isolates vary significantly in their biocontrol potential and suggests further exploration for developing S. rolfsii as an eco-friendly management strategy against Parthenium.